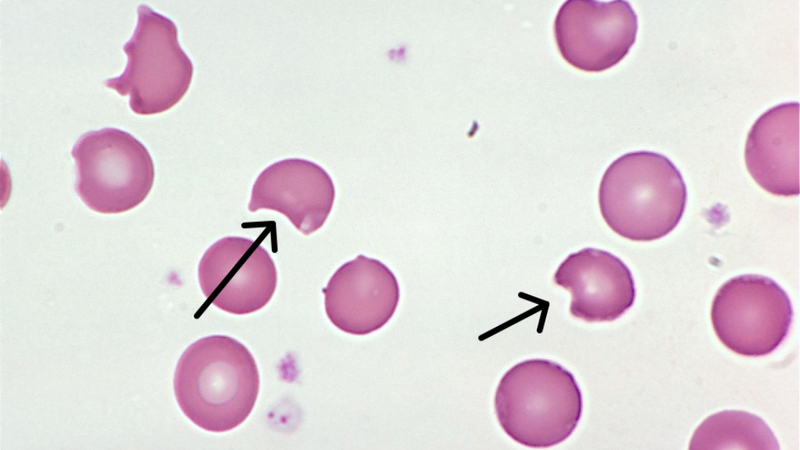
thuoc-ha-sot-cho-tre-thieu-g6-pd 1

Tốt nghiệp đại học Khoa Dược. Có kinh nghiệm hơn 10 năm trong lĩnh vực Dược phẩm, tư vấn thuốc và thực phẩm chức năng. Hiện đang là giảng viên cho Dược sĩ tại Nhà thuốc Long Châu.
Thục Hiền
26/04/2024
Mặc định
Lớn hơn
Trong quản lý tình trạng sốt ở trẻ, việc chọn lựa thuốc hạ sốt phù hợp là hết sức quan trọng, nhất là với những bé mắc bệnh thiếu men G6PD - một tình trạng di truyền có thể dẫn đến các phản ứng nguy hiểm khi sử dụng một số loại thuốc. Bài viết này cung cấp cái nhìn tổng quan về cách nhận biết và xử lý tình trạng sốt ở trẻ, đặc biệt là các lưu ý khi sử dụng thuốc hạ sốt cho trẻ thiếu G6PD, nhằm đảm bảo an toàn và hiệu quả, giúp bé nhanh chóng hồi phục mà không gặp phải rủi ro.
Trẻ em mắc bệnh thiếu men G6PD đứng trước nhiều thách thức khi cần sử dụng thuốc, đặc biệt là các loại thuốc hạ sốt. Với tình trạng này, việc lựa chọn loại thuốc hạ sốt cho trẻ thiếu G6PD sao cho an toàn và phù hợp trở nên cực kỳ quan trọng, vì một số loại thuốc có thể gây hại nghiêm trọng đến sức khỏe của bé. Bài viết dưới đây sẽ đề cập đến những điều cần biết và lưu ý khi chăm sóc và sử dụng thuốc hạ sốt cho trẻ thiếu G6PD, đặc biệt trong trường hợp trẻ bị sốt.
Bệnh thiếu men G6PD, hay còn được biết đến với tên gọi thiếu hụt glucose-6-phosphate dehydrogenase, là một rối loạn di truyền liên quan đến gen, chủ yếu ảnh hưởng đến nam giới. Men G6PD đóng một vai trò quan trọng trong quá trình chống oxy hóa của tế bào hồng cầu, giúp bảo vệ chúng khỏi các hậu quả có hại của quá trình oxy hóa.
Khi cơ thể thiếu hụt men này, tế bào hồng cầu trở nên yếu ớt và dễ vỡ, dẫn đến tình trạng thiếu máu tán huyết, đặc biệt khi bị phơi nhiễm với một số loại thực phẩm, hóa chất, hoặc thuốc. Sự thiếu hụt này không chỉ ảnh hưởng đến sức khỏe tổng quát của trẻ như làm tăng nguy cơ nhiễm khuẩn, mệt mỏi và vàng da, mà còn cản trở quá trình phát triển bình thường của trẻ.
Sử dụng thuốc cho trẻ mắc bệnh thiếu men G6PD yêu cầu sự cẩn trọng đặc biệt, bởi vì một số loại thuốc có thể kích thích quá trình hủy tế bào hồng cầu, gây ra các phản ứng tán huyết nghiêm trọng. Các loại thuốc thường gặp gồm có một số loại kháng sinh, thuốc hạ sốt như aspirin, và thậm chí là một số loại thực phẩm. Phản ứng này không chỉ làm tăng nhanh tình trạng thiếu máu, mà còn có thể gây ra các biến chứng nguy hiểm như suy gan, suy thận, hay tình trạng sốc.
Do đó, việc lựa chọn, sử dụng thuốc cho trẻ thiếu men G6PD cần phải dựa trên sự hiểu biết sâu sắc về bệnh và dưới sự giám sát chặt chẽ của bác sĩ để tránh những hậu quả đáng tiếc có thể xảy ra.
Sốt là một trong những dấu hiệu thường gặp nhất cho thấy trẻ có thể đang gặp vấn đề về sức khỏe. Ở trẻ em, nhiệt độ cơ thể bình thường dao động từ 36,5 đến 37,5 độ C. Sốt được xác định khi nhiệt độ cơ thể của trẻ cao hơn mức bình thường này. Các phụ huynh có thể nhận biết trẻ sốt thông qua các dấu hiệu như nhiệt độ cơ thể tăng, da trẻ nóng hơn bình thường khi chạm vào, đỏ bừng mặt, có thể kèm theo rùng mình, chán ăn, cáu kỉnh hoặc li bì.
Đối với trẻ thiếu men G6PD, việc nhận biết sớm tình trạng sốt là cực kỳ quan trọng để tránh những biến chứng nguy hiểm có thể xảy ra do phản ứng của một số loại thuốc hạ sốt.

Việc sử dụng thuốc hạ sốt cho trẻ thiếu G6PD cần được thực hiện một cách cẩn trọng. Paracetamol là lựa chọn hạ sốt an toàn, hiệu quả cho trẻ em, bao gồm cả những bé mắc bệnh thiếu men G6PD, với liều lượng phù hợp dựa trên cân nặng của trẻ và không được dùng quá thường xuyên (không dưới 6 tiếng mỗi lần sử dụng).
Ngoài ra, các phương pháp hạ sốt vật lý không cần sử dụng thuốc hạ sốt cho trẻ thiếu G6PD như sử dụng khăn ấm để lau người, cho trẻ mặc quần áo mỏng và giữ cho không gian xung quanh mát mẻ cũng rất hiệu quả. Các phụ huynh cũng nên đảm bảo trẻ được nghỉ ngơi và uống đủ lượng nước cần thiết để giúp cơ thể hồi phục. Trong trường hợp sốt cao không giảm sau khi đã áp dụng các biện pháp trên, cần đưa trẻ đến gặp bác sĩ ngay lập tức để được tư vấn và điều trị kịp thời, tránh các biến chứng nguy hiểm có thể xảy ra.
Trong số các lựa chọn thuốc hạ sốt cho trẻ, paracetamol nổi bật vì sự an toàn và hiệu quả của nó, đặc biệt đối với trẻ em mắc bệnh thiếu men G6PD. Paracetamol hoạt động bằng cách giảm nhiệt độ cơ thể mà không gây ra những phản ứng phụ nghiêm trọng liên quan đến hồng cầu, làm cho nó trở thành lựa chọn ưu tiên.
Tuy nhiên, việc sử dụng đúng liều lượng là vô cùng quan trọng để tránh những tác dụng phụ tiềm ẩn. Liều lượng khuyến cáo cho trẻ là khoảng 10 - 15 mg/kg cân nặng mỗi 4 - 6 giờ, nhưng không được vượt quá 60 mg/kg trong một ngày. Cần lưu ý rằng việc sử dụng quá liều có thể dẫn đến các vấn đề nghiêm trọng về gan và thậm chí tử vong.

Mặc dù paracetamol là lựa chọn an toàn, một số loại thuốc hạ sốt khác như aspirin (acetylsalicylic acid) và các thuốc chống viêm không steroid (NSAIDs) như ibuprofen, nên được hạn chế với trẻ mắc bệnh thiếu men G6PD do nguy cơ gây hủy hồng cầu cao.
Ngoài ra, một số loại thuốc kháng sinh và chống nấm cũng có thể gây hại cho trẻ thiếu men G6PD. Việc tư vấn với bác sĩ trước khi sử dụng bất kỳ loại thuốc nào kể cả thuốc hạ sốt cho trẻ thiếu G6PD là điều cực kỳ quan trọng, bởi vì một chẩn đoán chính xác và hiểu biết sâu sắc về tình trạng sức khỏe cụ thể của trẻ có thể hướng dẫn việc lựa chọn thuốc phù hợp và an toàn nhất. Bác sĩ cũng có thể cung cấp lời khuyên về các biện pháp hỗ trợ khác, giúp quản lý tình trạng sốt mà không cần đến thuốc, hoặc đề xuất các lựa chọn thay thế an toàn hơn cho trẻ.
Chăm sóc trẻ thiếu men G6PD đòi hỏi sự hiểu biết và quan tâm đặc biệt đến chế độ dinh dưỡng, cũng như các biện pháp hỗ trợ sức khỏe tổng thể. Dinh dưỡng cân đối không chỉ giúp tăng cường hệ miễn dịch, mà còn cung cấp một lớp bảo vệ khỏi các tác nhân có thể kích thích phản ứng tán huyết. Các bữa ăn giàu vitamin và khoáng chất, đặc biệt là các loại thực phẩm chứa vitamin C, E và các chất chống oxy hóa khác, có thể giúp cải thiện sức đề kháng của trẻ, giảm thiểu nguy cơ nhiễm trùng và hỗ trợ sức khỏe hồng cầu.
Tuy nhiên, cần tránh những thực phẩm gây hại như hạt fava (Hạt đậu tằm) và một số loại thuốc, hóa chất có thể kích thích phản ứng không mong muốn ở trẻ thiếu men G6PD.

Để quản lý và giám sát sức khỏe của trẻ mắc bệnh thiếu men G6PD một cách hiệu quả, việc thiết lập một kế hoạch theo dõi sức khỏe định kỳ là rất quan trọng. Điều này bao gồm việc lên lịch khám định kỳ với bác sĩ chuyên khoa để theo dõi tình trạng sức khỏe tổng thể và sự phát triển của trẻ, cũng như để phát hiện sớm bất kỳ dấu hiệu bất thường nào có thể xuất hiện.
Ngoài ra, việc giáo dục cho gia đình và người chăm sóc trẻ về tình trạng sức khỏe của trẻ, cách nhận biết các dấu hiệu cảnh báo sớm là rất cần thiết. Sự hiểu biết này giúp đảm bảo rằng trẻ nhận được sự chăm sóc và can thiệp kịp thời, tránh được biến chứng nghiêm trọng có thể xảy ra.
Trên đây là những thông tin về thuốc hạ sốt cho trẻ thiếu G6PD. Hy vọng bài viết đem đến nhiều kiến thức bổ ích cho bạn đọc.
Dược sĩ Đại họcNguyễn Thị Hồng Nhung
Tốt nghiệp đại học Khoa Dược. Có kinh nghiệm hơn 10 năm trong lĩnh vực Dược phẩm, tư vấn thuốc và thực phẩm chức năng. Hiện đang là giảng viên cho Dược sĩ tại Nhà thuốc Long Châu.